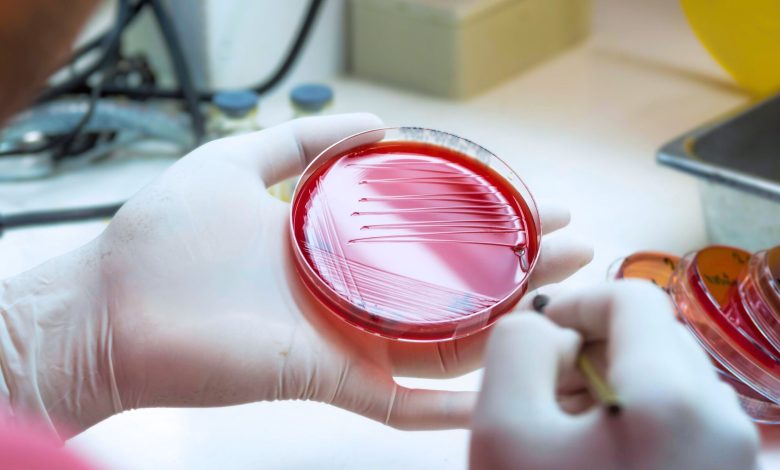

Bactérias estreptocócicas pouco conhecidas por trás do crescente número de infecções graves na Austrália

SDSE, um primo menos conhecido do estreptococo do grupo A, está a causar um número crescente de infecções graves em toda a Austrália, com as comunidades das Primeiras Nações a enfrentarem um risco três vezes maior de doença invasiva. Os investigadores do Instituto Doherty acompanharam mais de uma década de casos, revelando taxas crescentes, um clone bacteriano de rápida propagação e diferenças em relação ao estreptococo do grupo A – destacando necessidades urgentes de melhor vigilância, prevenção e potenciais vacinas. Crédito: Instituto Peter Doherty de Infecção e Imunidade
Uma bactéria estreptocócica pouco reconhecida está causando um número crescente de infecções graves na Austrália, com os australianos das Primeiras Nações afetados desproporcionalmente, de acordo com uma nova pesquisa publicada em O Micróbio Lanceta.
O estudo, liderado pelo Instituto Peter Doherty de Infecção e Imunidade (Instituto Doherty), examinou infecções invasivas causadas por Streptococcus dysgalactiae subespécie equisimilis (SDSE), um primo próximo do Streptococcus pyogenes (estreptococo do grupo A ou Strep A). Tal como o estreptococo do grupo A, o SDSE pode causar infecções na pele e nos tecidos moles e, em casos graves, invadir o sangue e os órgãos, levando a doenças potencialmente fatais.
Pela primeira vez, os pesquisadores mediram a carga de infecções invasivas por SDSE em toda a Austrália, comparando as tendências no sudeste da Austrália e no Top End do Território do Norte. A equipe analisou mais de uma década de dados clínicos e genômicos de hospitais de todas as regiões.
Com base em pesquisas anteriores sobre o estreptococo do grupo A, eles compararam a incidência, a demografia e os resultados das infecções invasivas por SDSE (iSDSE) com as do estreptococo invasivo do grupo A (iGAS), descobrindo diferenças importantes na forma como os dois patógenos se espalham e quem eles afetam.
Ouli Xie, da Universidade de Melbourne, pesquisador clínico do Laboratório Davies-Tong do Instituto Doherty e primeiro autor do artigo, disse que o estudo revelou taxas crescentes de infecção e disparidades entre regiões.
“Descobrimos que, em áreas urbanas no sudeste da Austrália, as infecções por iSDSE ocorreram a uma taxa semelhante à do iGAS e aumentaram constantemente entre 2011 e o início de 2023. Nas regiões remotas do norte, o iSDSE era menos comum do que o iGAS, mas o número de casos ainda era 25% maior do que no sudeste da Austrália”, disse o Dr.
“Durante anos, o SDSE foi visto como um fator menor em comparação com o estreptococo do grupo A, mas nosso estudo mostra que ele está causando uma carga significativa e crescente de doenças graves na Austrália, predominantemente em australianos mais velhos”.
O professor associado da Universidade de Melbourne, Mark Davies, chefe do laboratório do Instituto Doherty e co-autor principal, disse que a análise genômica de amostras de pacientes revelou insights importantes.
“O sequenciamento do genoma revelou que, embora o SDSE e o estreptococo do grupo A estejam intimamente relacionados, eles se comportam de maneira diferente em termos de transmissão e recorrência, e afetam as populações de maneira diferente”, disse o professor associado Davies.
“Isto sugere que as estratégias de controlo utilizadas para o iGAS, como administrar antibióticos a contactos próximos, podem não funcionar tão bem para o iSDSE”.
A equipa também descobriu que mais de um em cada quatro casos estava ligado ao stG62647, um clone bacteriano da SDSE que se espalha rapidamente na Europa e na América do Norte, e agora na Austrália.
O professor Steven Tong, do Royal Melbourne Hospital, chefe de grupo e pesquisador clínico do Instituto Doherty e co-autor principal, disse que as descobertas lançam luz sobre as desigualdades de saúde enfrentadas pelos australianos das Primeiras Nações em regiões remotas.
“Dentro do próprio Top End, que já tinha taxas mais altas de iSDSE do que o sudeste da Austrália, os australianos das Primeiras Nações foram ainda mais desproporcionalmente afetados, enfrentando mais de três vezes o risco de doença invasiva em comparação com indivíduos não pertencentes às Primeiras Nações”, disse o professor Tong.
“Precisamos urgentemente de estratégias que abordem os determinantes sociais da saúde que impulsionam este fardo, bem como de novas abordagens para prevenir e tratar infecções invasivas por estreptococos”.
Juntamente com a investigação anterior da equipa iGAS, as descobertas fornecem o quadro mais abrangente até à data da doença estreptocócica invasiva na Austrália.
Destacam a necessidade urgente de melhorar a vigilância, a prevenção em comunidades vulneráveis e a exploração de vacinas ou terapêuticas, com parceiros da indústria como a Moderna já manifestando interesse nos dados genómicos com o objectivo de desenvolver uma vacina que possa funcionar tanto contra a SDSE como contra o estreptococo do grupo A.
Mais informações:
Xie O, et al. Invasivo Streptococcus dysgalactiae subespécie equisimilis comparado com Streptococcus pyogenes na Austrália, 2011–23, e o surgimento de uma linhagem stG62647 multicontinente: um estudo retrospectivo de epidemiologia clínica e genômica. O Micróbio Lanceta. DOI: 10.1016/j.lanmic.2025.101182
Fornecido pelo Instituto Peter Doherty de Infecção e Imunidade
Citação: Bactérias estreptocócicas pouco conhecidas por trás do número crescente de infecções graves na Austrália (2025, 8 de outubro) recuperadas em 8 de outubro de 2025 em https://medicalxpress.com/news/2025-10-strep-bacteria-severe-infections-australia.html
Este documento está sujeito a direitos autorais. Além de qualquer negociação justa para fins de estudo ou pesquisa privada, nenhuma parte pode ser reproduzida sem permissão por escrito. O conteúdo é fornecido apenas para fins informativos.

